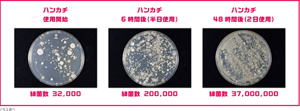
ハンカチ使用開始 細菌数 32,000 ハンカチ6時間後(半日使用) 細菌数 200,000 ハンカチ48時間後(2日使用) 細菌数 37,000,000 ※花王調べ
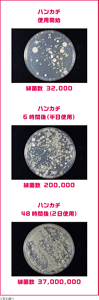
ハンカチ使用開始 細菌数 32,000 ハンカチ6時間後(半日使用) 細菌数 200,000 ハンカチ48時間後(2日使用) 細菌数 37,000,000 ※花王調べ

例えば、30代男性では、女性の2倍皮脂がでます。適度な皮脂は外界から異物が侵入するのを防ぎ、肌からの水分蒸散を抑制する役割があります。しかし、皮脂が過剰に分泌されると、紫外線や空気に触れ、酸化することで肌に悪影響を与えることもあります。
過剰な皮脂はそのままにしておかないことが、男のスキンケアでは大切です。




ハンカチやタオルを携帯されてる方も多いと思いますが、ちょっと覚えておいたほうがいいことがあります。
実は、汗をふいて湿ったハンカチは、雑菌の温床になりやすいと言われているのです。さらに、汗をふくだけでなく、手洗いのあとにも使うなど、1日何度も使うなかで、雑菌の繁殖は増える一方です。下記の実験では半日後になんと約6.25倍の細菌が増殖するという結果に!せっかく汗をふくのだから、清潔なハンカチでふきたいですね。常にフレッシュに使えるフェイスシートがおすすめです。